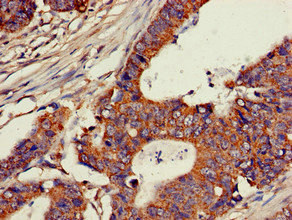
CSB-PA005307LA01HU

CH25H
CH25H,全稱為膽固醇25-羥化酶,也被稱為膽固醇25-單加氧酶。該蛋白在細胞內脂類代謝過程中扮演重要角色,能夠催化膽固醇生成25-羥基膽甾醇。CH25H蛋白在多種疾病中發揮作用,如腸道病毒感染、阿爾茨海默病和腫瘤。在腸道病毒感染中,CH25H蛋白能夠抑制病毒的復制;在阿爾茨海默病中,其與疾病進展有關;在腫瘤免疫治療中,CH25H蛋白的調控能夠影響巨噬細胞的免疫抑制功能。目前,針對CH25H蛋白的藥物研發正在逐步推進,有望為相關疾病的治療提供新的策略。
熱銷產品
CH25H Antibody (CSB-PA005307LA01HU)
驗證數據
Immunohistochemistry of paraffin-embedded human colon cancer using CSB-PA005307LA01HU at dilution of 1:100

Immunohistochemistry of paraffin-embedded human kidney tissue using CSB-PA005307LA01HU at dilution of 1:100
CH25H Antibodies
CH25H for Homo sapiens (Human)
| 產品貨號 | 產品名稱 | 種屬反應性 | 應用類型 |
|---|---|---|---|
| CSB-PA005307LA01HU | CH25H Antibody | Human | ELISA, IHC |
| CSB-PA005307LB01HU | CH25H Antibody, HRP conjugated | Human | ELISA |
| CSB-PA005307LD01HU | CH25H Antibody, Biotin conjugated | Human | ELISA |
CH25H Proteins
CH25H Proteins for Homo sapiens (Human)
| 產品貨號 | 產品名稱 | 來源 |
|---|---|---|
| CSB-YP005307HU1 CSB-EP005307HU1 CSB-BP005307HU1 CSB-MP005307HU1 CSB-EP005307HU1-B |
Recombinant Human Cholesterol 25-hydroxylase (CH25H), partial | Yeast E.coli Baculovirus Mammalian cell In Vivo Biotinylation in E.coli |
| CSB-CF005307HU | Recombinant Human Cholesterol 25-hydroxylase (CH25H) | in vitro E.coli expression system |














